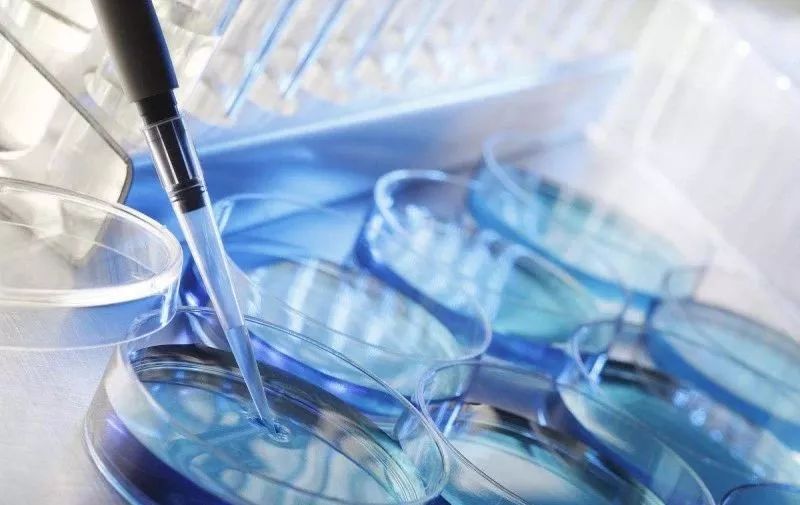
试管婴儿,心理压力,调节心态的办法

如今,随着社会的发展,越来越多的不孕不育患者使用试管婴儿来怀上自己的孩子,但是对于许多准妈妈来说,治疗的过程是非常痛苦的,长期的注射、药物、提取卵子、移植胚胎... 有如此多的不确定性,准妈妈的情绪也难免会受其影响,所以整个试管婴儿治疗的过程,心理压力会影响到婴儿吗?
今天爱生育健康专家跟大家分析一下,试管婴儿期间,哪个阶段的心理反应最大?
-
不孕女性在同一治疗时间周期的不同发展阶段的心理反应是通过不同的。在治疗方法开始,胚胎移植之前和移植之后,妊娠试验前一周以及对于妊娠测试当天,心理环境压力影响最大。
-
压力的强度随连续失败的治疗周期而变化。 第一个周期的压力与不理解治疗过程的盲目乐观有关。 第三个周期(通常是最后一个周期)的压力与失败原因不明和治疗前景混乱有关。
-
多周期治疗失败者的心理压力主要与经济负担、夫妻感情、家庭关系有关。
-
后续影响。虽然试管婴儿是成功的,但是没有根本治疗不孕症,因此与不孕相关的负面情绪是很难克服的。

面对巨大的心理压力,我们虽然不能完全克服,但是可以努力想办法应对试管婴儿的心理失衡。
-
知道什么是试管婴儿
试管婴儿是一种助孕技术,但是未必一定能够成功,试管婴儿过程可能发生各种情况。 患者在选择试管婴儿前应了解自己的情况,客观评估自己的成功率,不要盲目乐观或自我怀疑,还要了解试管婴儿在每个准备阶段,可能发生的情况,以及如何做好准备。
-
信任医生
你的主治医生是你的坚实后盾。一旦你进入试管婴儿的治疗,就必须完全信任你的医生。毕竟,医生最了解你的健康。如果对药物的反应过大,可以与医生沟通,不要擅自停药。
-
夫妻应互相鼓励
怀孕从来都不是一个人可以完成的事情。不管谁负责,都要互相支持。试管婴儿的丈夫也在积极配合检查调理。在试管婴儿治疗中,女性比男性承受更多的压力和痛苦。准爸爸们应该更了解他们的妻子,更多地互相帮助。互相鼓励,互相加油,互相鼓励。
-
及时释放不良情绪
如果我们您对试管婴儿有不良影响情绪,应及时发泄自己情绪,并找人谈论。例如,一个闺蜜或者丈夫。
-
心理咨询
如果夫妇在试管婴儿过程中的心理压力太大,传统方法无法缓解,可以寻求心理学家的干预,进行心理咨询。 一个人的生活有很多困难,当他们遇到困难时,他们会积极寻求帮助,并让医生帮助。 不孕本身和治疗过程是一个压力事件。 如果在治疗过程中心理严重“不适”,建议咨询专业心理专家。






















 医院 · 516多所试管婴儿医院
医院 · 516多所试管婴儿医院
 医生 · 2497位试管婴儿医生
医生 · 2497位试管婴儿医生
 同龄 · 100万姐妹试管好孕群
同龄 · 100万姐妹试管好孕群
